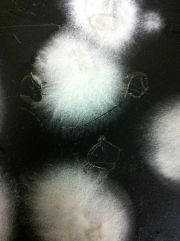
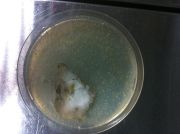
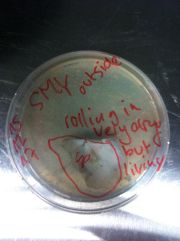
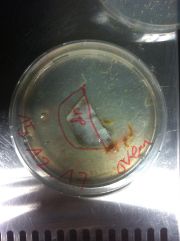
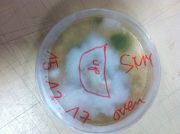
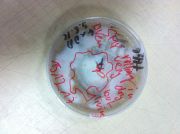

This special page shows all uploaded files.
| Date | Name | Thumbnail | Size | Description | Versions |
|---|---|---|---|---|---|
| 16:21, 10 January 2018 | Someone-making-photos.jpg (file) |  |
59 KB | File uploaded with MsUpload | 1 |
| 16:38, 10 January 2018 | Conatmination-just-cutted-out.JPG (file) |  |
2.1 MB | File uploaded with MsUpload | 1 |
| 16:40, 10 January 2018 | Hole-where-the contamination-was.JPG (file) | |
1.95 MB | File uploaded with MsUpload | 1 |
| 16:48, 10 January 2018 | Potatoes-cooking.JPG (file) |  |
2.24 MB | File uploaded with MsUpload | 1 |
| 16:50, 10 January 2018 | Taking-them-out.JPG (file) |  |
1.89 MB | File uploaded with MsUpload | 1 |
| 16:52, 10 January 2018 | Agar&Dextrose.JPG (file) |  |
1.68 MB | File uploaded with MsUpload | 1 |
| 16:54, 10 January 2018 | Burned-Pot.JPG (file) |  |
1.72 MB | File uploaded with MsUpload | 1 |
| 16:57, 10 January 2018 | Filled-Petridishes.JPG (file) |  |
2.27 MB | File uploaded with MsUpload | 1 |
| 17:24, 10 January 2018 | Me-waiting.JPG (file) |  |
131 KB | File uploaded with MsUpload | 1 |
| 17:26, 10 January 2018 | Experiment-30.11.JPG (file) |  |
2.01 MB | File uploaded with MsUpload | 1 |
| 17:31, 10 January 2018 | IMG 1265.JPG (file) |  |
1.42 MB | File uploaded with MsUpload | 1 |
| 17:31, 10 January 2018 | IMG 1266.JPG (file) | |
1.71 MB | File uploaded with MsUpload | 1 |
| 17:31, 10 January 2018 | IMG 1267.JPG (file) | |
1.55 MB | File uploaded with MsUpload | 1 |
| 17:31, 10 January 2018 | IMG 1268.JPG (file) |  |
1.58 MB | File uploaded with MsUpload | 1 |
| 17:31, 10 January 2018 | IMG 1269.JPG (file) |  |
1.75 MB | File uploaded with MsUpload | 1 |
| 17:31, 10 January 2018 | IMG 1271.JPG (file) |  |
1.7 MB | File uploaded with MsUpload | 1 |
| 17:31, 10 January 2018 | IMG 1272.JPG (file) |  |
1.7 MB | File uploaded with MsUpload | 1 |
| 17:31, 10 January 2018 | IMG 1273.JPG (file) |  |
1.84 MB | File uploaded with MsUpload | 1 |
| 17:31, 10 January 2018 | IMG 1255.JPG (file) |  |
1.72 MB | File uploaded with MsUpload | 1 |
| 17:31, 10 January 2018 | IMG 1256.JPG (file) | |
1.69 MB | File uploaded with MsUpload | 1 |
| 17:31, 10 January 2018 | IMG 1257.JPG (file) |  |
1.76 MB | File uploaded with MsUpload | 1 |
| 17:31, 10 January 2018 | IMG 1258.JPG (file) |  |
1.62 MB | File uploaded with MsUpload | 1 |
| 17:31, 10 January 2018 | IMG 1260.JPG (file) |  |
1.47 MB | File uploaded with MsUpload | 1 |
| 17:31, 10 January 2018 | IMG 1261.JPG (file) |  |
1.52 MB | File uploaded with MsUpload | 1 |
| 17:31, 10 January 2018 | IMG 1262.JPG (file) |  |
1.55 MB | File uploaded with MsUpload | 1 |
| 17:31, 10 January 2018 | IMG 1263.JPG (file) |  |
1.38 MB | File uploaded with MsUpload | 1 |
| 17:31, 10 January 2018 | IMG 1264.JPG (file) |  |
1.51 MB | File uploaded with MsUpload | 1 |
| 17:35, 10 January 2018 | IMG 1343.JPG (file) | |
2.04 MB | File uploaded with MsUpload | 1 |
| 17:35, 10 January 2018 | IMG 1344.JPG (file) |  |
1.99 MB | File uploaded with MsUpload | 1 |
| 17:35, 10 January 2018 | IMG 1345.JPG (file) | |
2.01 MB | File uploaded with MsUpload | 1 |
| 17:35, 10 January 2018 | IMG 1346.JPG (file) |  |
2.01 MB | File uploaded with MsUpload | 1 |
| 17:35, 10 January 2018 | IMG 1347.JPG (file) |  |
2.16 MB | File uploaded with MsUpload | 1 |
| 17:35, 10 January 2018 | IMG 1348.JPG (file) |  |
2.03 MB | File uploaded with MsUpload | 1 |
| 17:35, 10 January 2018 | IMG 1339.JPG (file) |  |
1.84 MB | File uploaded with MsUpload | 1 |
| 17:35, 10 January 2018 | IMG 1340.JPG (file) |  |
1.91 MB | File uploaded with MsUpload | 1 |
| 17:35, 10 January 2018 | IMG 1341.JPG (file) |  |
2.04 MB | File uploaded with MsUpload | 1 |
| 17:35, 10 January 2018 | IMG 1342.JPG (file) |  |
2.16 MB | File uploaded with MsUpload | 1 |
| 17:45, 10 January 2018 | IMG 1351.JPG (file) |  |
2.19 MB | File uploaded with MsUpload | 1 |
| 17:45, 10 January 2018 | IMG 1352.JPG (file) |  |
2.25 MB | File uploaded with MsUpload | 1 |
| 17:45, 10 January 2018 | IMG 1353.JPG (file) |  |
2.27 MB | File uploaded with MsUpload | 1 |
| 17:45, 10 January 2018 | IMG 1349.JPG (file) |  |
2.18 MB | File uploaded with MsUpload | 1 |
| 17:45, 10 January 2018 | IMG 1350.JPG (file) |  |
2.22 MB | File uploaded with MsUpload | 1 |
| 18:32, 14 January 2018 | PA300839.JPG (file) |  |
1.36 MB | File uploaded with MsUpload | 1 |
| 18:42, 14 January 2018 | PA310871.JPG (file) |  |
1.23 MB | File uploaded with MsUpload | 1 |
| 18:47, 14 January 2018 | PA310847.JPG (file) |  |
1.46 MB | File uploaded with MsUpload | 2 |
| 18:56, 14 January 2018 | PA310850.JPG (file) |  |
1.43 MB | File uploaded with MsUpload | 5 |
| 18:57, 14 January 2018 | PA310848.JPG (file) |  |
1.41 MB | File uploaded with MsUpload | 3 |
| 18:59, 14 January 2018 | PA310855.JPG (file) |  |
1.49 MB | File uploaded with MsUpload | 2 |
| 19:00, 14 January 2018 | PA310851.JPG (file) |  |
1.31 MB | File uploaded with MsUpload | 2 |
| 19:01, 14 January 2018 | PA310866.JPG (file) |  |
1.42 MB | File uploaded with MsUpload | 2 |